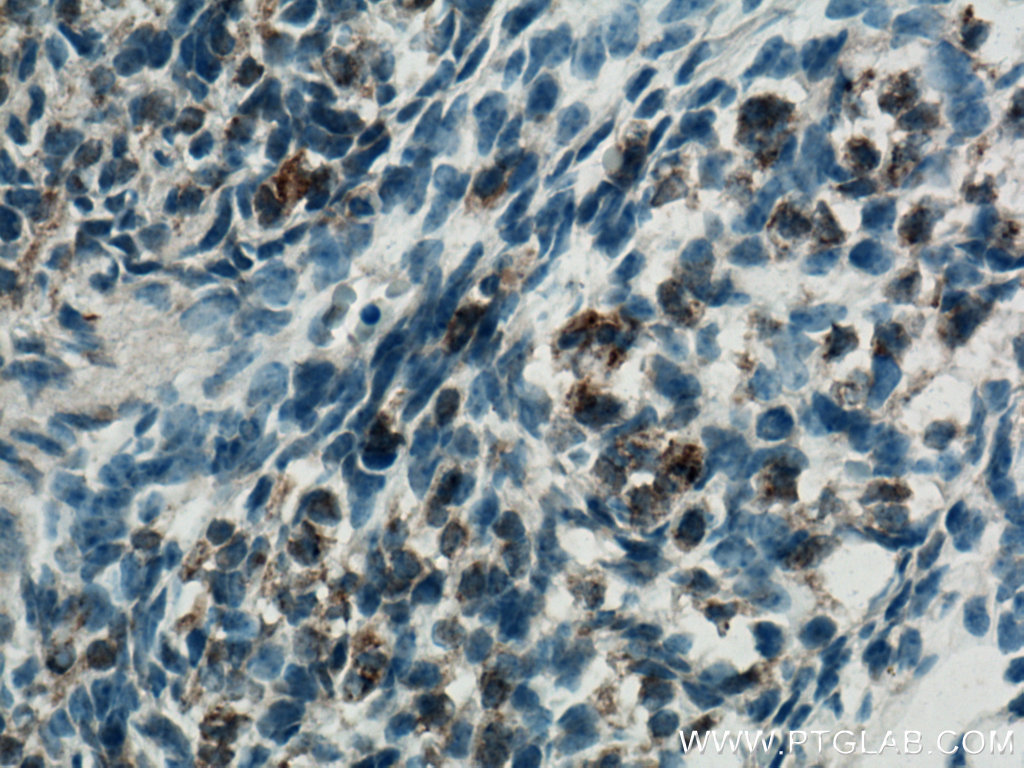

验证数据展示
经过测试的应用
| Positive IHC detected in | mouse kidney tissue, mouse embryo tissue, mouse heart tissue Note: suggested antigen retrieval with TE buffer pH 9.0; (*) Alternatively, antigen retrieval may be performed with citrate buffer pH 6.0 |
| Positive IF/ICC detected in | HepG2 cells |
推荐稀释比
| 应用 | 推荐稀释比 |
|---|---|
| Immunohistochemistry (IHC) | IHC : 1:50-1:500 |
| Immunofluorescence (IF)/ICC | IF/ICC : 1:200-1:800 |
| It is recommended that this reagent should be titrated in each testing system to obtain optimal results. | |
| Sample-dependent, Check data in validation data gallery. | |
产品信息
11495-1-AP targets FGF18 in WB, IHC, IF/ICC, ELISA applications and shows reactivity with human, mouse samples.
| 经测试应用 | IHC, IF/ICC, ELISA Application Description |
| 文献引用应用 | WB, IHC, IF |
| 经测试反应性 | human, mouse |
| 文献引用反应性 | human, mouse |
| 免疫原 |
CatNo: Ag2041 Product name: Recombinant human FGF18 protein Source: e coli.-derived, PKG Tag: GST Domain: 1-207 aa of BC006245 Sequence: MYSAPSACTCLCLHFLLLCFQVQVLVAEENVDFRIHVENQTRARDDVSRKQLRLYQLYSRTSGKHIQVLGRRISARGEDGDKYAQLLVETDTFGSQVRIKGKETEFYLCMNRKGKLVGKPDGTSKECVFIEKVLENNYTALMSAKYSGWYVGFTKKGRPRKGPKTRENQQDVHFMKRYPKGQPELQKPFKYTTVTKRSRRIRPTHPA 种属同源性预测 |
| 宿主/亚型 | Rabbit / IgG |
| 抗体类别 | Polyclonal |
| 产品类型 | Antibody |
| 全称 | fibroblast growth factor 18 |
| 别名 | zFGF5, UNQ420/PRO856, Fibroblast growth factor 18, FGF-18, FGF 18 |
| 计算分子量 | 207 aa, 24 kDa |
| GenBank蛋白编号 | BC006245 |
| 基因名称 | FGF18 |
| Gene ID (NCBI) | 8817 |
| RRID | AB_2877770 |
| 偶联类型 | Unconjugated |
| 形式 | Liquid |
| 纯化方式 | Antigen affinity purification |
| UNIPROT ID | O76093 |
| 储存缓冲液 | PBS with 0.02% sodium azide and 50% glycerol, pH 7.3. |
| 储存条件 | Store at -20°C. Stable for one year after shipment. Aliquoting is unnecessary for -20oC storage. |
背景介绍
FGF18 is a member of the fibroblast growth factor (FGF) family. FGF family members possess broad mitogenic and cell survival activities, and are involved in a variety of biological processes, including embryonic development, cell growth, morphogenesis, tissue repair, tumor growth, and invasion. It has been shown in vitro that this protein is able to induce neurite outgrowth in PC12 cells. Studies of the similar proteins in mouse and chick suggested that this protein is a pleiotropic growth factor that stimulates proliferation in a number of tissues, most notably the liver and small intestine. Knockout studies of the similar gene in mice implied the role of this protein in regulating proliferation and differentiation of midline cerebellar structures.
实验方案
| Product Specific Protocols | |
|---|---|
| IF protocol for FGF18 antibody 11495-1-AP | Download protocol |
| IHC protocol for FGF18 antibody 11495-1-AP | Download protocol |
| Standard Protocols | |
|---|---|
| Click here to view our Standard Protocols |
发表文章
| Species | Application | Title |
|---|---|---|
Front Pharmacol Suppression of FGF5 and FGF18 Expression by Cholesterol-Modified siRNAs Promotes Hair Growth in Mice. | ||
J Exp Clin Cancer Res HDAC7 promotes NSCLC proliferation and metastasis via stabilization by deubiquitinase USP10 and activation of β-catenin-FGF18 pathway. | ||
Ann Transl Med Cucurbitacin promotes hair growth in mice by inhibiting the expression of fibroblast growth factor 18 | ||
Life Sci BUB1 potentiates gastric cancer proliferation and metastasis by activating TRAF6/NF-κB/FGF18 through m6A modification | ||
Adv Healthc Mater Targeted Therapy of Osteoarthritis via Intra-Articular Delivery of Lipid-Nanoparticle-Encapsulated Recombinant Human FGF18 mRNA | ||
J Nanobiotechnology Delivery of FGF18 using mRNA-LNP protects the cartilage against degeneration via alleviating chondrocyte senescence |